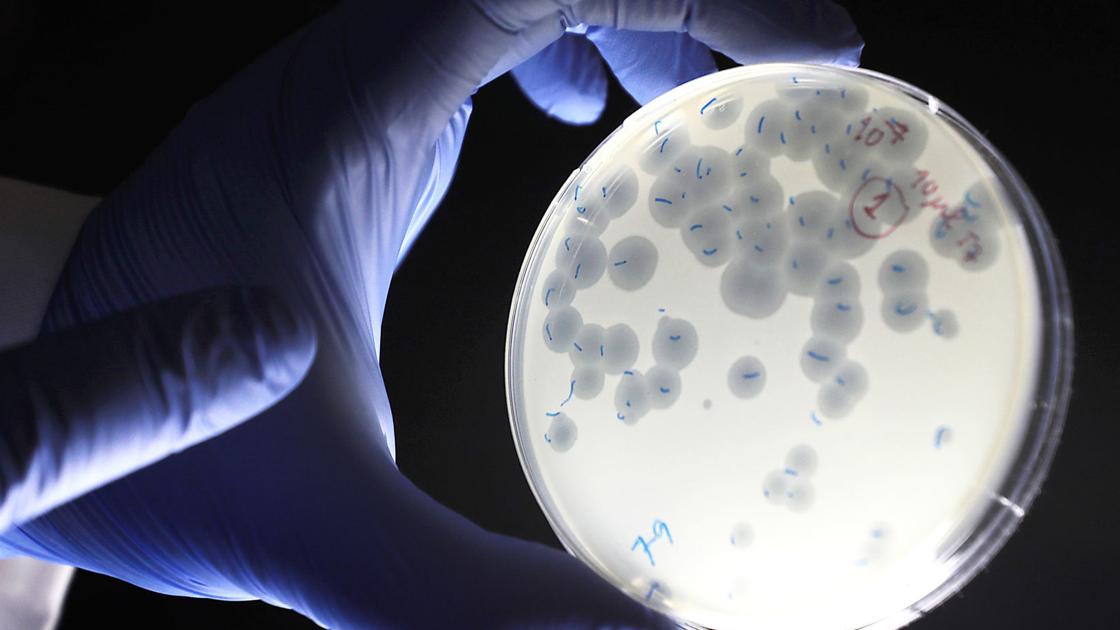
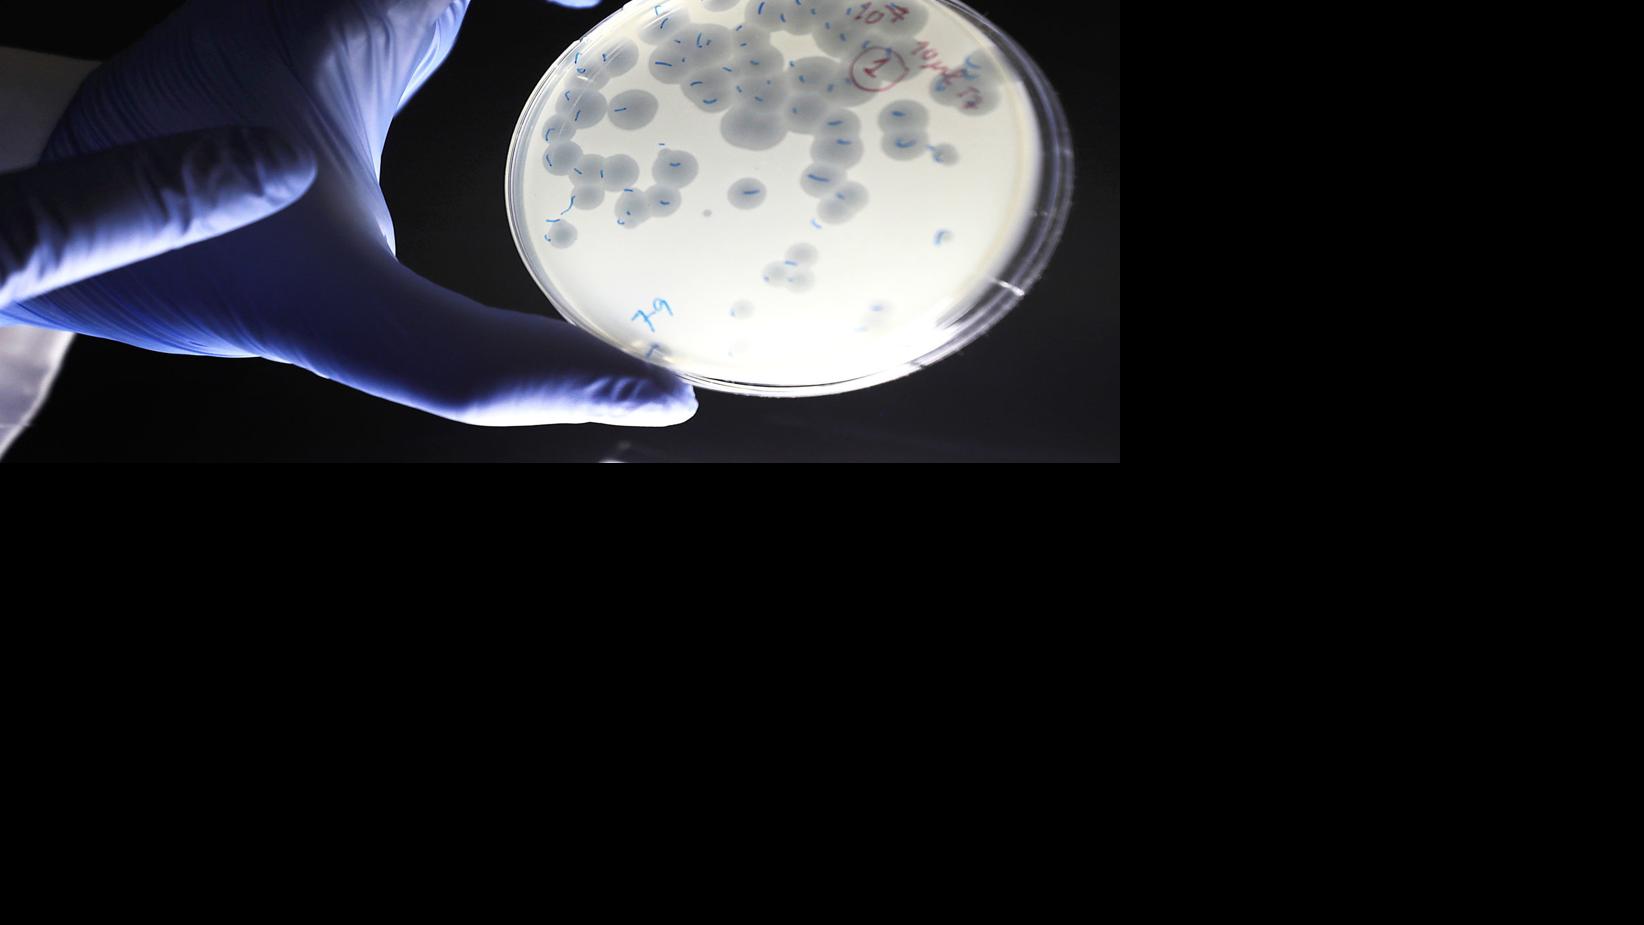

Asked nearly two years ago what he might do with his considerable wealth, the world's richest person Jeff Bezos said "space travel" was his only option.
"The only way that I can see to deploy this much financial resource is by converting my Amazon winnings into space travel," the Amazon founder said , adding that he was "liquidating" about $1 billion a year in Amazon stock to fund his space business, Blue Origin. "That is basically it."
But space travel might not be enough for Bezos these days. Over the past week, he unloaded roughly $4 billion of stock as Amazon's market cap closed above $1 trillion for the first time, Bloomberg reported. That brings Bezos's total stock sales to more than $14 billion, mostly over the past four years. His net worth is estimated at $127 billion, or roughly 2 million times the median US household income.
Not to change the topic here:
Space Coast Has Once-in-a-Generation Opportunity to Support New Type of Commercial Space Business

THE SPACE COAST, FLORIDA • USA – Fifty years ago, an exceptional generation of men and women helped launch Americans into space and land NASA astronauts on the Moon.
Today, the next generation of space travel is increasing the launch tempo on Florida's Space Coast and creating new business opportunities for launch support services that have not been seen before.
New launchers like Vulcan, Firefly Alpha, Relativity Space, Omega, New Glenn, and RocketLab will require highly efficient approaches to final flight hardware integration and testing that do not rely on traditional government operations and contractors.
UW study in space explores new way to treat bacterial infections: phage therapy | Local News |
Plaques of phages, viruses that infect bacteria, in a plate of E.coli bacteria. A UW-Madison biochemist is sending phages and bacteria to the International Space Station for an experiment on how microgravity and radiation affect the viruses' ability to treat antibiotic-resistant infections.
A UW-Madison scientist's experiment at the International Space Station, scheduled to be launched by rocket Sunday, could help identify new treatments for antibiotic-resistant bacteria and keep astronauts healthy during space travel.
Bacteria, bone and more: Here's the science launching to the space station Sunday | Space

NASA is launching a bevy of crew supplies and scientific cargo to the International Space Station Sunday (Feb. 9) from NASA's Wallops Flight Facility in Virginia.
Also onboard the spacecraft will be a variety of experiments and pieces of research equipment. These will support investigations on topics including tissue and cell cultures and biofuels.
* * *
A new miniature biology lab is headed to the space station on the Cygnus capsule. Dubbed the Mobile SpaceLab, the system is a technology-demonstration project that scientists hope could demonstrate a new way to conduct experiments in orbit. That's because Mobile SpaceLab is a tissue- and cell-culturing facility designed to function autonomously, running an experiment for up to one month without using precious astronaut time .
While you're here, how about this:
New NASA Glenn director has UT ties, sees 'bright future' for northern Ohio | Toledo Blade

Astronaut Christina Koch lands back on Earth after a record-breaking 328 days in space | WQAD.com

(CNN) — NASA astronaut Christina Koch made the most of her first trip to the International Space Station by breaking the record for the longest single spaceflight by a woman and conducting the first all-female spacewalk with fellow NASA astronaut Jessica Meir.
“We caught each other’s eye and we knew that we were really honored with this opportunity to inspire so many, and just hearing our voices talk to Mission Control, knowing two female voices had never been on the loops, solving those problems together outside — it was a really special feeling,” Koch said of that first spacewalk, on October 18.
Deals of the week: Business class award space, West Coast to Europe for under $300 and more

Each Sunday, we round up the top deals you might have missed on TPG this week. From flight deals to limited-time bonus offers, here's what you need to know.
* * *
Why we love it: Scoring award seats for a whole family doesn’t come around often. Airlines love to restrict space until the last second, which means a nail-biting waitlist experience — or worse — getting stuck in economy.
CARD HIGHLIGHTS: 2X points on all travel and dining, points transferrable to over a dozen travel partners
Virgin Galactic to take first space tourists this year, technology expert predicts | Arab News

HELSINKI, Finland: Tourism is bound for new heights with the first space tourists predicted to suit up and travel beyond Earth's atmosphere later this year, according to a space technology expert.
Darren Trofimczuk, an educational technology expert and lecturer at Finland's Haaga-Helia University, predicted that Virgin Galactic, part of British billionaire Sir Richard Branson's Virgin Group empire, will be the first among the three key players to commercially fly tourists to space.
Happening on Twitter
Amazon CEO Jeff Bezos shares the career advice he gives his kids. (via @CNBCMakeIt) https://t.co/jwUzVR0p2c CNBC (from Englewood Cliffs, NJ) Sun Feb 09 04:01:23 +0000 2020
.@JeffBezos has said he sells about $1 billion worth of @Amazon stock annually to fund @blueorigin, but this week w… https://t.co/VjMea2Qf66 b0yle (from Seattle) Fri Feb 07 22:20:21 +0000 2020
Amazon CEO Jeff Bezos sells $3.5 billion worth of shares in one week https://t.co/urOZZnu13y https://t.co/GAqt65Xdx1 nypost (from New York, NY) Fri Feb 07 17:28:05 +0000 2020
Jeff Bezos is finding he can spend money on things other than space travel https://t.co/pWtsxtR0f3 qz (from The World) Sun Feb 09 15:02:32 +0000 2020

No comments:
Post a Comment